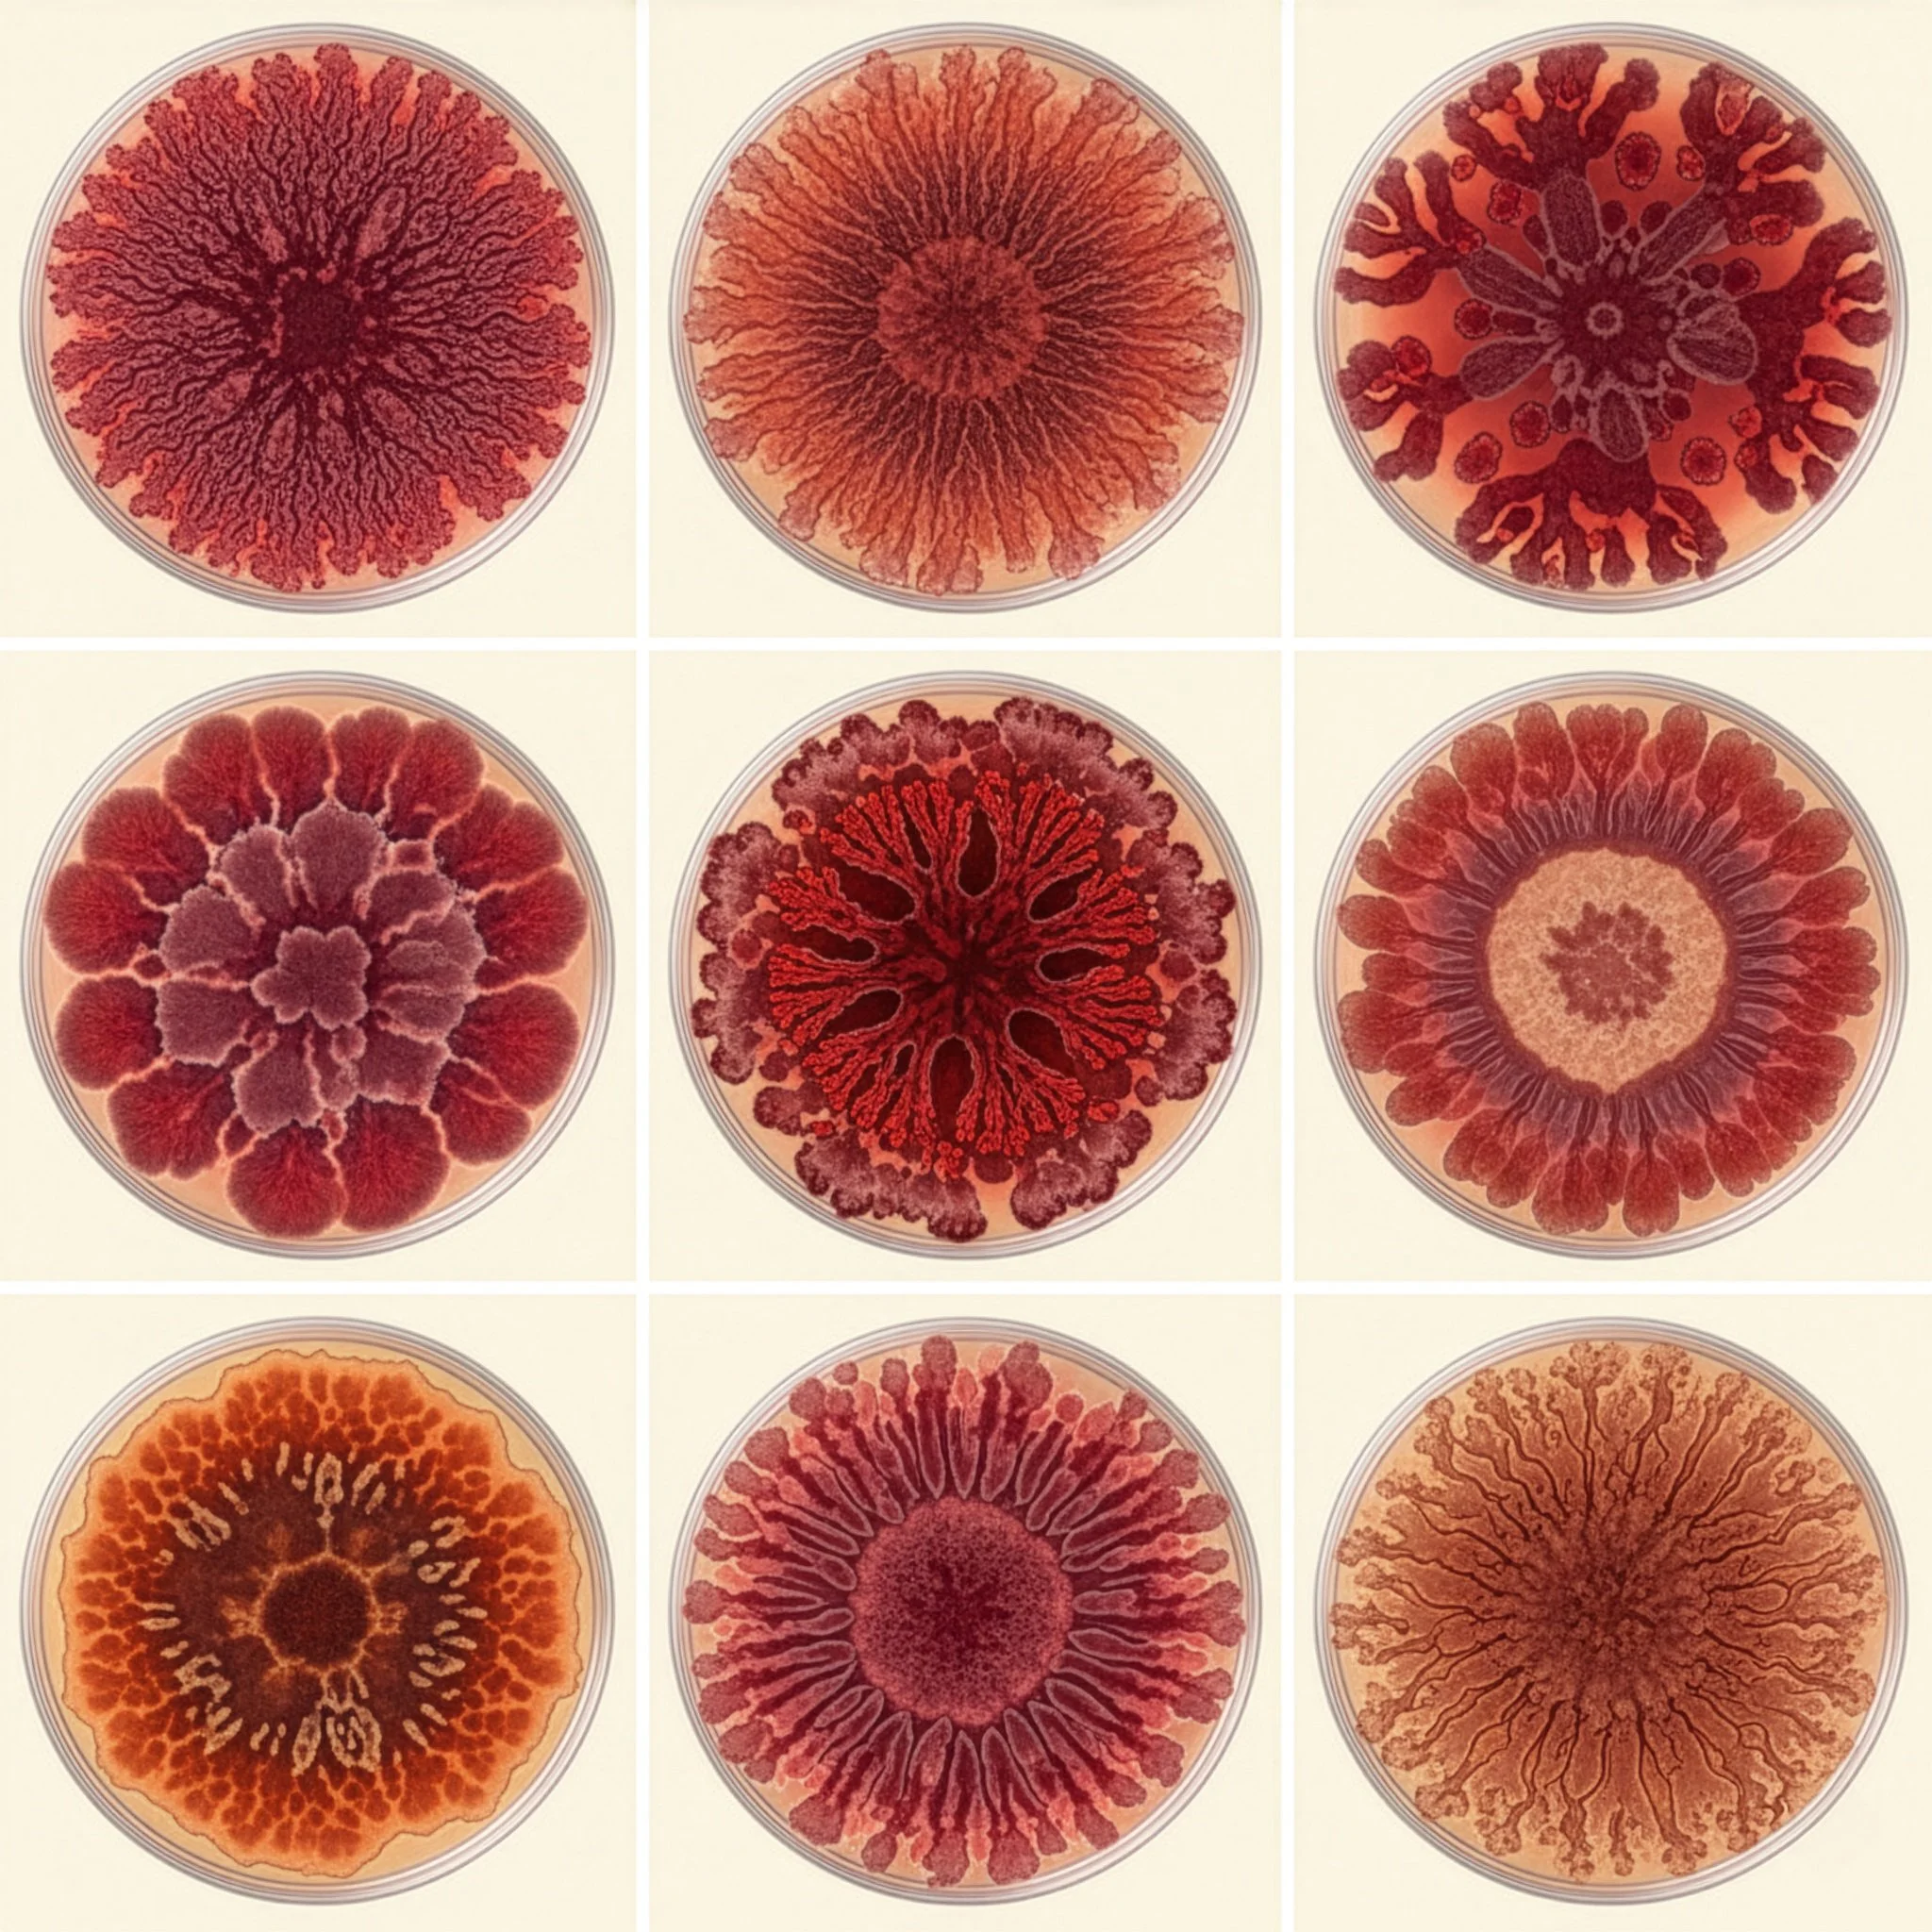

Biology is powerful. But slow.
Traditional fermentation depends on time, variability, and limited control. Industrial food systems demand precision, scalability, and predictability.
THE RESULT:
INEFFICIENT MATURATION CYCLES
limited reproducibility
Additive Compensation
EXTENDED PROCESSING TIMES
Sporalys engineers biological performance into industrial systems.
Sporalys develops natural functional food ingredients through a proprietary solid-state fermentation platform powered by advanced bioprocessing, directed evolution, and artificial intelligence.
We optimize the interaction between Aspergillus oryzae and food substrates to deliver scalable, reproducible performance, enhancing efficiency, functionality, and sensory impact at industrial scale.
OUR TECHNOLOGYOne Platform. Three Integrated Layers.
AI-guided strain–substrate matching.
We model enzymatic expression, metabolic pathways, and substrate compatibility to design optimized biological systems.
Capabilities include:
Enzyme activity profiling
Substrate performance mapping
Directed evolution pipelines
Predictive sensory modeling
Solid-State Biomanufacturing engineered for industry.
Our modular SSF systems enable controlled biological transformation under reproducible industrial conditions.
Designed for:
Batch scalability
Industrial substrate adaptability
Low-water processing
Integration into existing production lines
Industrial-grade validation.
We quantify biological output to ensure consistency, repeatability, and measurable performance gains.
Validation includes:
Enzymatic activity quantification
Metabolomic characterization
Sensory performance validation
Process integration modeling
THE BIOLOGICAL COREEngineering Koji for Industry
At the core of the Sporalys Platform is Aspergillus oryzae, the microorganism behind traditional koji fermentation.
Sporalys re-engineers this biology for industrial precision, enhancing enzymatic activity, metabolite production, and flavor expression at scale.
